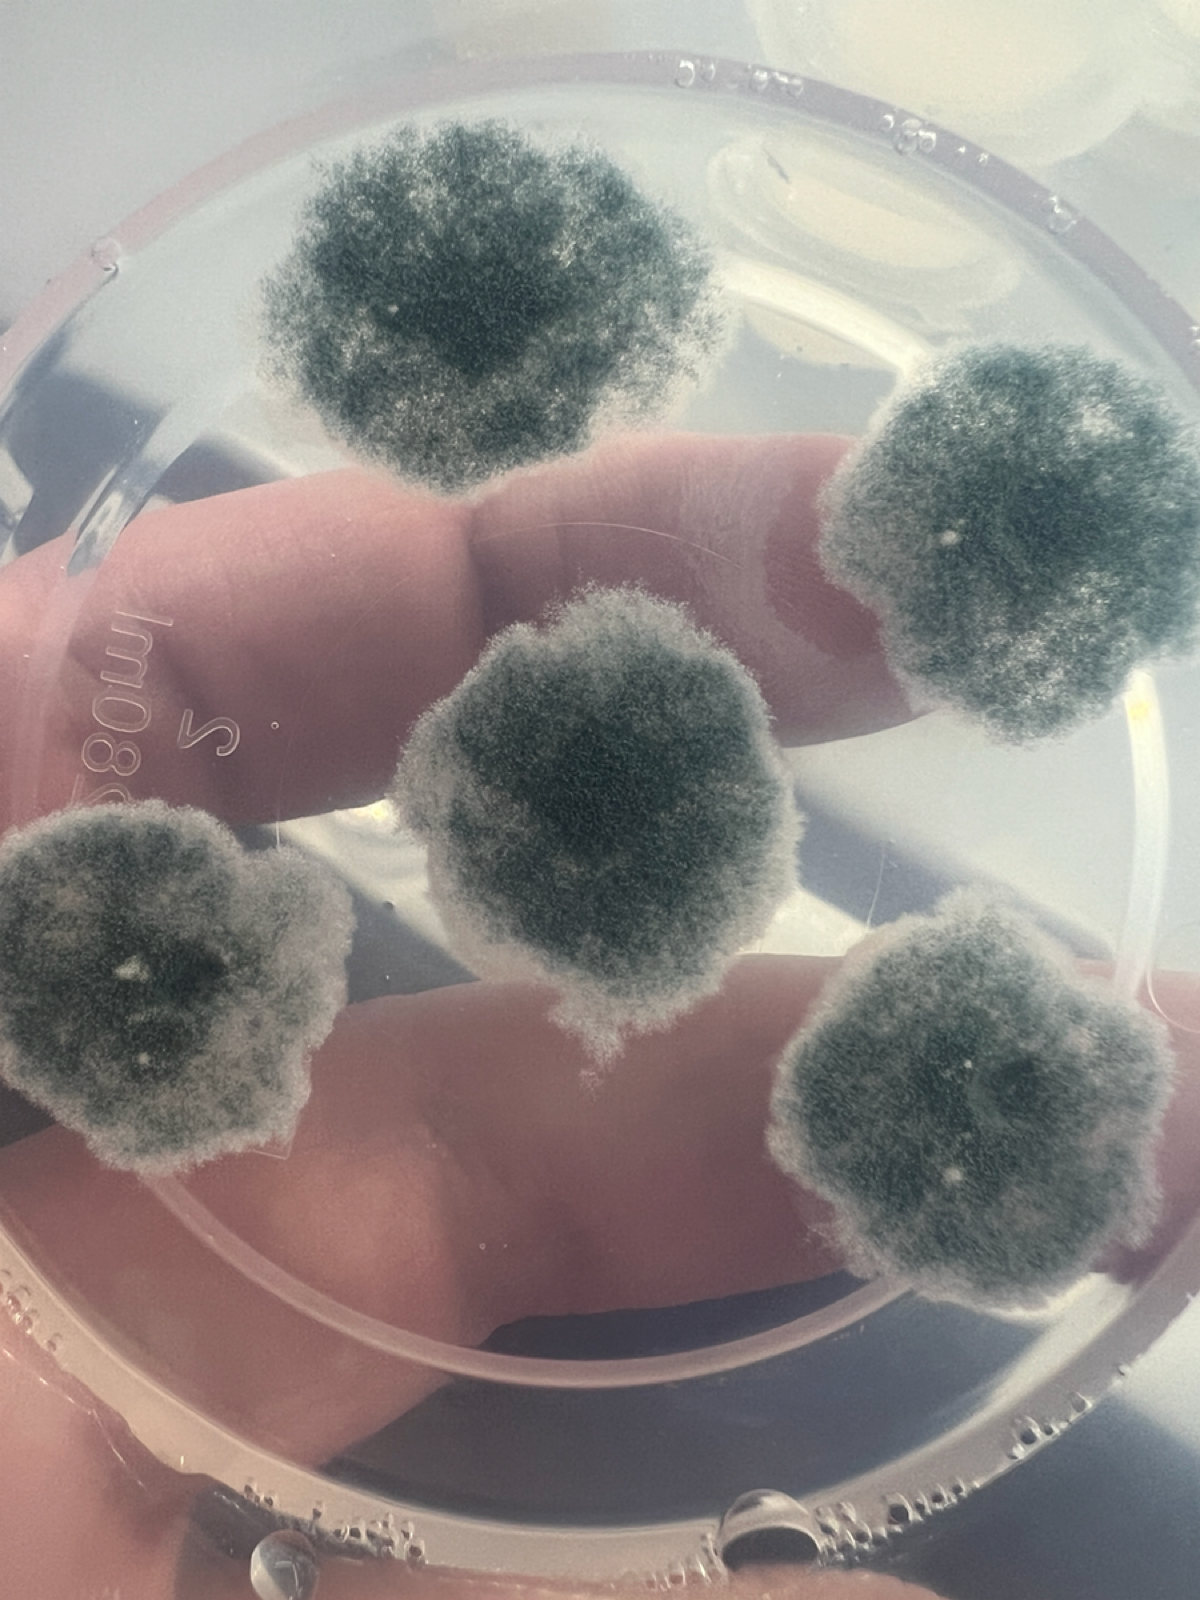
Проект «Плесень» | Сетка — социальная сеть от hh.ru

Проект «Плесень»
Я люблю хороший сыр с плесенью. С 2014 года он полностью пропал с прилавков магазинов. Удивительно то, что до сих пор весь сыр с голубой плесенью, который продают у нас в магазинах, полная дрянь. Почему-то колу из Грузии и Польши привозят, а сыр окольными путями не везут. Разве что в некоторые подпольные места, где если точку закроют, то терять нечего.
Для сыра с голубой плесенью используют вид Penicillium roqueforti. Вот только у всех, кто его использует у нас получается не вкусно, а у итальянцев — вкусно. Считаю, что основная проблема в штамме этой самой плесени. Так что я решил не только бороться с плесенью, но и выращивать. У меня и лаборатория есть.
Купил сыру от топового итальянского производителя, да и посадил плесени у себя в ламинаре. Приготовлю сыр. Посмотрим, что получится.